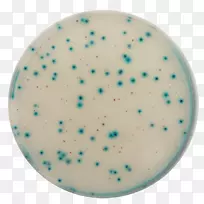
生长介质水分检测分析水化学微生物学-水-空若网 生长介质水分检测分析水化学微生物学-水-空若网

欢迎您 本站地址:
首页
图片素材
采购产品服装配件 角度 线-图片素材分享-空若网

图片素材推荐-空若网

绿松石设计

胡萝卜 复活节 绿松石色

水组织鱼图设计.水
生长介质水分检测分析水化学微生物学-水

png图片剪辑艺术泪滴拖车透明摄像机.水瓶

护目镜太阳镜

桌面壁纸动物电脑剪贴画电脑

医用口罩 外科口罩 蓝色

潜水国际水下潜水播音员-人

编辑桌面壁纸夹艺术-油漆

天空-降雨图片

投资图标 奖励图标 绿色

计算机图标设计握手-云共享

鞋跟凉鞋

弹簧框架 装饰框架 绿色

蓝色 绿松石色 水绿色

绿松石设计

水蓝 绿松石 天蓝

产品设计绿松石字体.土坯插画.不规则线条

蓝色 圆形 浅绿色

品牌电脑图标剪贴画设计

眼镜 太阳镜 水蓝

粉红m线字形线

火炬图标 电子设备图标 手电筒图标

标志产品设计品牌字号标志

线条三角形标志字体线

水塑绿松石-冰块

产品设计线角线
温馨提示 扫描下方二维码,访问手机版。

